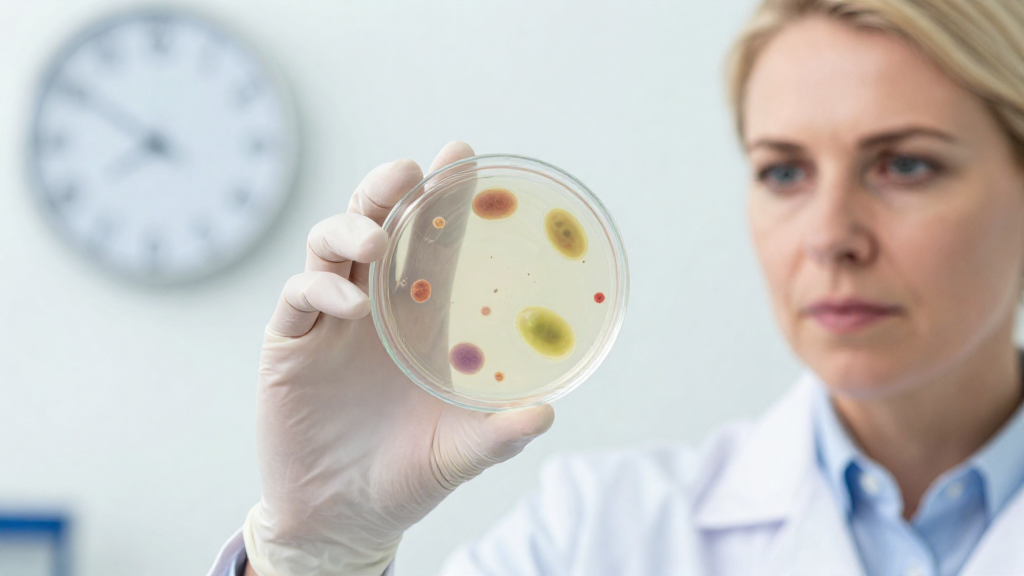
What Is the Typical Timeline of a Foodborne Illness

Understanding the foodborne illness timeline is crucial for recognizing symptoms and seeking timely treatment.
Foodborne illnesses, commonly known as food poisoning, occur when food or beverages contaminated with harmful bacteria, viruses, or parasites are consumed.
In this article, we will explore the various stages of a foodborne illness, how long it takes to manifest, and what you should do if you suspect an infection.
How Long Does It Take for Symptoms to Appear?
The foodborne illness timeline can vary significantly depending on several factors, including:
– Type of pathogen.
– Amount of contaminated food consumed.
– Individual health conditions.
Incubation Period
After ingesting contaminated food, the incubation period rolls into play. This is the time between consuming the contaminated food and the onset of symptoms. It can range from a few hours to several days—here are some common pathogens for comparison:
- Salmonella: 6 hours to 6 days
- Norovirus: 12 to 48 hours
- E. coli: 1 to 10 days
- Listeria: 1 to 4 weeks
What Symptoms Should You Expect?
After the incubation period, symptoms can manifest. The foodborne illness timeline reflects the progression from mild discomfort to severe symptoms. Typical symptoms may include:
- Nausea
- Vomiting
- Diarrhea
- Abdominal Pain
- Fever
Generally, symptoms may begin mildly and worsen over a course of days or even weeks.
How Long Do the Symptoms Last?
The duration of symptoms can significantly differ based on the specific pathogen. Here’s a brief overview:
- Salmonella: 4 to 7 days
- Norovirus: 1 to 3 days
- E. coli: 5 to 10 days
- Listeria: Can persist for several weeks, particularly in severe cases
Most foodborne illnesses resolve on their own.
However, some people, especially young children, the elderly, or immunocompromised individuals, can exhibit more severe symptoms or complications.
When Should You Seek Medical Attention?
It’s essential to be aware of when to escalate your care. Monitor your symptoms according to the foodborne illness timeline guidelines:
Red Flags
You should seek immediate medical attention if you experience:
- Dehydration: Symptoms include excessive thirst, dry mouth, little or no urination, or weakness.
- High Fever: A temperature of 101°F (38.3°C) or higher should be taken seriously.
- Severe Abdominal Pain.
- Persistent Vomiting or Diarrhea: This could signal a more serious infection.
- Bloody Stool.
What are the Treatment Options?
While most foodborne illnesses will resolve on their own, treatment can sometimes be necessary. Here are some treatment options based on the foodborne illness timeline and your symptoms:
Home Remedies
For mild cases, the following may help relieve symptoms:
- Hydration: Drink fluids, preferably water or electrolyte solutions, to prevent dehydration.
- Rest: Focus on keeping your body strong to fight off the illness.
- BRAT Diet: Bananas, Rice, Applesauce, and Toast can help ease the stomach when you begin to feel better.
Medical Treatment
In some instances, you may need prescription medications or treatments. Your healthcare provider might recommend:
- Antibiotics: Usually reserved for severe bacterial infections.
- Intravenous (IV) Fluids: To combat dehydration.
- Specialized Treatment: For specific pathogens, like antiviral prescriptions for norovirus.
How Can You Prevent Foodborne Illness?
Understanding the foodborne illness timeline underscores the importance of food safety precautions. Here are some effective ways to reduce the risk of foodborne illnesses:
Safe Food Handling Practices
Adopt these safe practices when preparing or consuming food:
- Wash Hands: Properly wash hands before and after food preparation.
- Separate Raw and Cooked Foods: Use separate cutting boards to avoid cross-contamination.
- Cook Thoroughly: Ensure food reaches the appropriate internal temperature.
- Store Food Properly: Use refrigeration and freezing to keep food safe.
Awareness of Food Sources
Knowing where your food comes from can help minimize risks. Make informed choices by:
- Choosing Reputable Suppliers: Purchase food from trusted sources or local farmers’ markets.
- Checking Expiration Dates: Always pay attention to expiration and sell-by dates.
Conclusion
Understanding the foodborne illness timeline helps individuals know what to expect when facing potential food poisoning, from the incubation period to symptom resolution.
By recognizing the symptoms and acting promptly, you can enhance your recovery and prevent complications.
Remember, practicing safe food handling and being aware of your food sources significantly reduces the chances of contracting a foodborne illness.
For your well-being, ensure to stay informed, prepared, and prioritize food safety in every meal you consume!